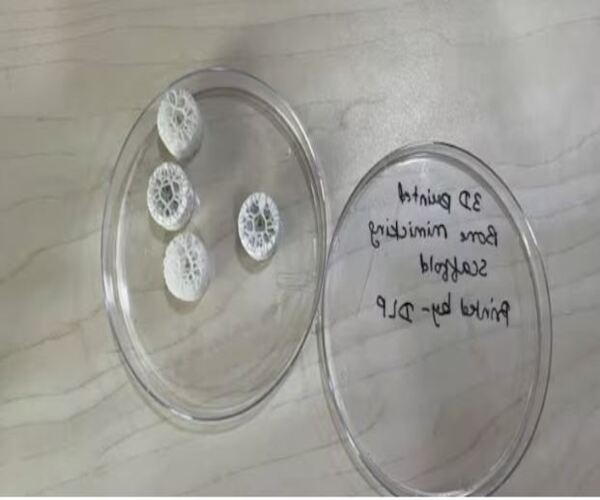
IITમાં બન્યું સિન્થેટિક બોન

Home health-lifestyle
health-lifestyle
દિલને રાખો ટનાટન: આ પ્રકારની મહિલાઓમાં ઓછો રહે છે હાર્ટ અટેકનો ખતરો, તમે પણ રાખો ધ્યાન

ગરમ મસાલાના ફાયદા અને નુકસાન બન્ને: ભોજનમાં ઉપયોગમાં લેતા પહેલા આ આર્ટિકલ વાંચી લો

વેલેઈન્ટાન્સ પર ન કરો આ ભૂલ: પ્રેમના પર્વ પર પાર્ટનરને કદી પણ ન આપો આ ભેટ...

ઈન્ટરમિટન્ટ ફાસ્ટિંગની ટિપ્સ: 40 વર્ષ બાદ ઈન્ટરમિટન્ટ ફાસ્ટિંગ કરવું જોઈએ કે નહીં, આ ખાસ જાણી લો

શરીર હળવું થશે ખિસ્સા નહીં: આ રહ્યા વજન ઘટાડવાના બજેટમાં સમાય તેવા નુસખા

ફેંગશુઈ ટિપ્સ: કરિયરમાં સફળતાની સીડી ચડવા કરો આ કામ

ભીના વાળમાં ન કરો આ ભૂલ: આ 7 ભૂલો ક્યારેય ન કરો, તે કાયમ માટે ખરાબ સાબિત થશે

આ વળી અચાનક હાથ-પગ જકડાઈ કેમ જતા હશે?: કયા વિટામીનની ઉણપના કારણે થાય છે આ સમસ્યા?

આદત હૈ જીત કી: હાર નથી માનતા આ પાંચ રાશિવાળા, જીતની આદત છે એમની

ડિહાઈડ્રેશનથી બચવા તમે તો વધારે પડતું પાણી નથી પી જતા ને?: વધારે પડતું પાણી પીવું પણ વધારી શકે મુશ્કેલી

બિહારમાં મખાના બોર્ડ બનાવવામાં આવશે: મોતી જેવા આ સફેદના દાણા કઈ રીતે હોય છે સ્વાસ્થ્ય માટે વરદાન?

Propose day 2025: એવું તો શુ કરવું કે તમારા એકરાર વિના જ તમારો ક્રશ હા કહી દે?

Prayagraj famous street food: જો પ્રયાગરાજ જાઓ છો તો આ 5 સ્વાદિષ્ટ વાનગીઓ ખાઈ લેજો

IITમાં બન્યું સિન્થેટિક બોન: હવે હાડકાના કેન્સર અને ઈન્ફેક્શનના ઈલાજમાં મળશે મદદ
સ્કાલ્પમાં આવે છે ખંજવાળ?: બસ આટલુ કરો..મજા પડી જશે

સફેદ વાળને કુદરતી રીતે કરો કાળા: આ ઉપાય ચાર અઠવાડિયામાં વાળને આપશે નવું જીવન

આ એક ભૂલ કરી તો ડાયાબિટીસ થવાનું ફાઈનલ: મોડું થાય તે પહેલા જ સુધારી લો આ આદત

સહિયર સખીઓ માટે ખાસ: આ 4 પ્રકારની બ્રા મહિલાઓ માટે ખૂબ જ ખતરનાક છે, ખરીદતા પહેલા ધ્યાન રાખો

શું યમુનાનું પાણી પીવા અને નહાવા લાયક છે?: શું કહે છે નિષ્ણાતો?

રાતભર પલાળો સુકાયેલી દ્રાક્ષ: સવારે બની જશે શીલાજીતનો બાપ

